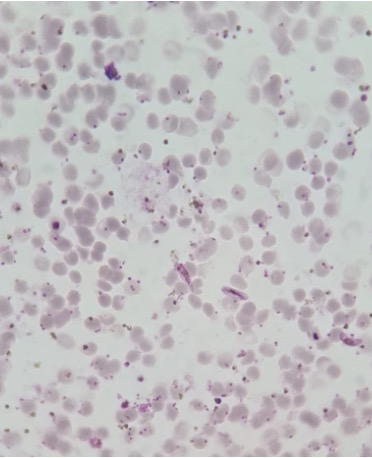
<p></p>
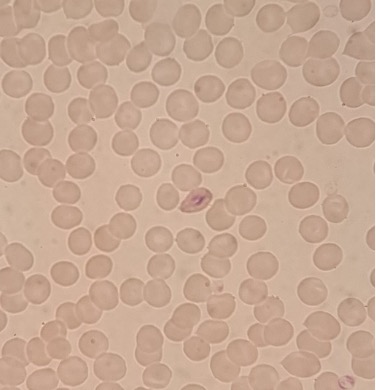
term image
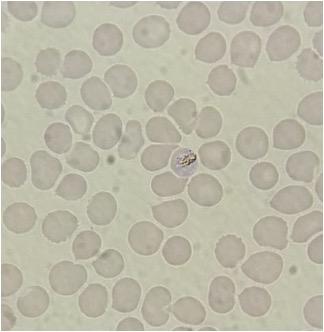
term image
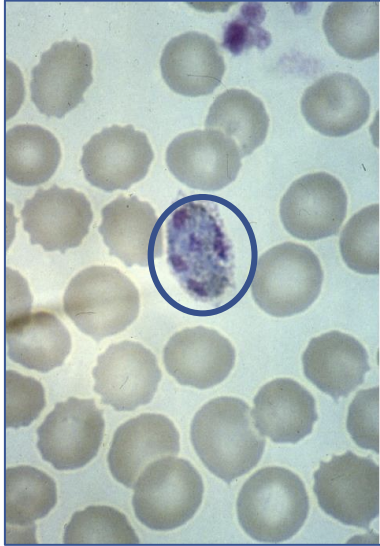
term image
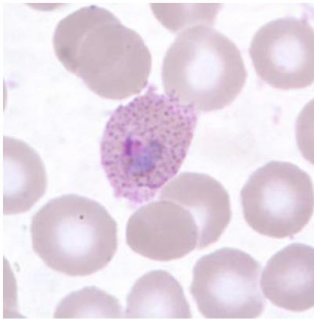
term image
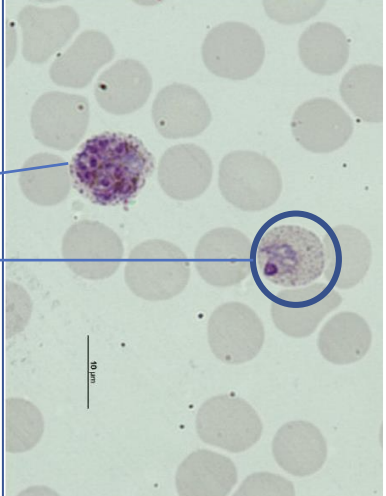
term image
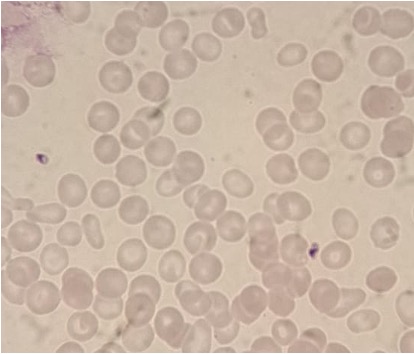
term image
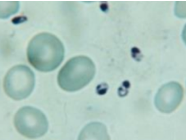
term image
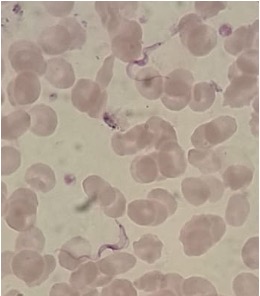
term image

1/62
Looks like no tags are added yet.
Name | Mastery | Learn | Test | Matching | Spaced |
|---|
No study sessions yet.
Elevada Parasitémia
Gametócitos em forma de foice
Grande número de trofozoítos jovens
→ Plamodium falciparum

Esquizonte jovem :
- eritrócitos polimórficos
- poucos merozóitos
- sem granulações
→ Plasmodium vivax

Esquizonte maduro :
- Eritrócitos polimórficos
- poucos merozóitos
- sem granulações
→ Plasmodium vivax
Trofozoíto jovem :
- forma oval
→ Plasmodium ovale
Trofozoíto jovem :
- eritrócito parasitado mais pequeno que o não parasitado
- sem granulações
→ Plasmodium malariae

Esquizonte maduro :
- poucos merozóitos
- eritrócito parasitado mais pequeno que os não parasitados
→ Plasmodium malariae

Parasitemia elevada
O eritrócito parasitado parece apresentar o mesmo tamanho que o não parasitado.
Presença de Eritrócito binucleado, triparasitado e biparasitado.
Não existem granulações.
→ Plasmodium falciparum

Gametócito em forma de banana
→ Plasmodium falciparum
O parasita é grande e encontra-se dentro do eritrócito.
Esse mesmo eritrócito parasitado é maior que os não parasitados.
Tem Granulação de Schuffner (á volta).
Apresenta 5 peças de núcleo ainda grossas (ainda vão dividir-se e ficando mais finas). Logo é um Esquizonte jovem!
A célula parasitária é oval. No entanto não se pode garantir que se trata de P. ovale. (Se as células ovais se repetirem na presença de elementos parasitários é que se torna relevante!)
→ Plasmodium vivax ou Plasmodium ovale.
Forma ovalada não muito pronunciada mas com franja!
Elemento parasitário com um só núcleo e o citoplasma não é anelar - Trofozoíto maduro.
Apresenta Granulações de Schuffner
→ Plasmodium ovale.
Trofozoíto maduro – com 1 núcleo e citoplasma grosso.
Granulações de Schuffner
Gametócito
Eritrócitos parasitados maiores que os não parasitados.
→ Plasmodium vivax ou ovale.

Imagem 1:
Gametócito com 1 núcleo mais avermelhado no centro.
Célula parasitada maior que a não parasitada.
Granulações de Schuffner.
Imagem 2:
Esquizonte maduro com um elevado número de Merozoítos
Não é possível a visualização das granulações de Schuffner no eritrócito parasitado pois este está quase a arrebentar.
Os Esquizontes jovens e maduros geralmente não aparecem no sangue periférico no Plasmodium falciparum. No entanto, se houver uma Parasitemia muito elevada (que não é o caso da imagem) estas formas desta espécie podem aparecer no sangue periférico.
→ Esquizonte maduro de Plasmodium vivax!
Formas amastigotas de Leishmania spp.
Formas amastigotas de Leishmania spp.

Formas promastigotas de Leishmania spp.

Quisto cheio de bradizoítos de Toxoplasma gondii

Trofozoítos intracelulares de Toxoplasma gondii
Formas tripomastigota de Trypanossoma spp.

Quisto de Entamoeba coli

Quisto de Entamoeba coli

Quisto de Endolimax nana

Quisto de Endolimax nana

Quisto de Iodamoeba buschii

Quisto de Iodamoeba buschii

Quisto de Iodamoeba buschii

Quisto de Giardia lamblia

Quisto de Giardia lamblia

Oocisto de Cryptosporidium spp.

Oocisto de Cryptosporidium spp.

Trofozoítos de Trichomonas vaginalis

Trofozoítos de Trichomonas vaginalis

Ovo de Fasciola hepatica

Ovo de Fasciola hepatica

Ovo de Fasciola hepatica

Verme adulto de Fasciola hepatica na lupa

Verme adulto de Fasciola hepatica na lupa

Ovo de Schistosoma mansoni

Ovo de Schistosoma mansoni

Ovo de Schistosoma haematobium

Vermes adultos de Schistosoma na lupa (possível ver um casal de parasitas)

Ovo de Schistosoma intercalam

Ovos de Taenia spp.

Larvas de Cysticercus cellulose em carne de porco à lupa

Ovo de Hymenolepsis nana

Ovo de Hymenolepsis nana

Porção de estróbilo de Hymenolepsis nana

Ovo de Diphylobotium latum

Ovo de Diphylobotium latum

Ovo embrionado de Ascaris lumbricoides

Ovo fértil cortinado de Ascaris lumbricoides

Ovo de Ascaris lumbricoides

Ovo não embrionado de Ascaris lumbricoides

Ovo de Trichuris trichiura

Ovos de Trichuris trichiura

Vermes adultos de Trichuris trichiura na lupa

Vermes adultos na lupa

Ovos de Enterobius vermicularis

Ovo de Enterobius vermicularis

Verme adulto de Enterobius vermicularis na lupa

Ancilostomídeos na lupa

Ovos de Ancilostomídeos

Ovo de Ancilostomídeo

Larva de Strongyloides stercoralis